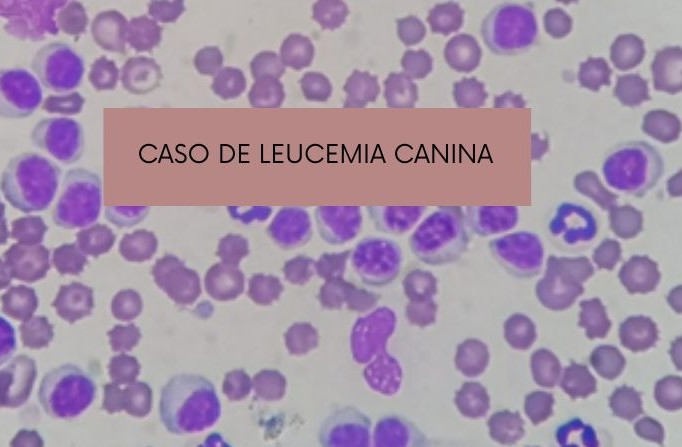

La leucemia es una neoplasia hematopoyética poco frecuente en caninos, caracterizada por comportamiento agresivo y evolución rápida. Se describe el caso clínico de una perra mestiza de 10 años que presentó signos inespecíficos como decaimiento progresivo e inapetencia. TAGS: Leucemia canina. Frotis sanguíneo. Leucocitosis. Diagnóstico hematológico. Medicina veterinaria
AUTORES: De la Cruz Valdivia, Sarahi Montserrat¹; Cano Escobedo, Yutzil Jocabeth¹; Becerra Peña, Alejandra2; Gianfelici, Mario Federico3; Zarabanda Pinzón, Yuliana4*
¹ Laboratorista, Laboratorio de Patología Clínica Veterinaria, Lab For Vets®
2Clinica veterinaria Von Haus Precman 3Área Científica, Lab For Vets® ³ Director Clínico, Laboratorio de Patología Clínica Veterinaria, Lab For Vets®
*Autor de correspondencia: direccion@labforvets.com
Acceder al trabajo en archivo adjunto.

No hay comentarios aún.